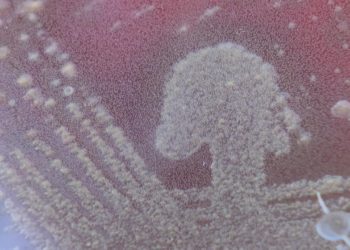

Le sepsis, affection sous-estimée qui fait 4000 morts par année en Suisse
Chaque année, 4000 personnes décèdent dans les hôpitaux suisses à cause d’un sepsis, une réaction anormale et incontrôlée du corps à une infection, notamment lorsque le sang est envahi de ...